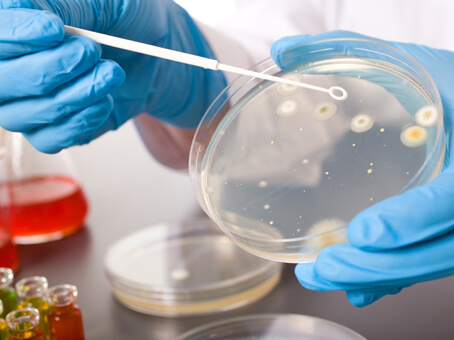
microbiology

General pathology is a speciality concern with all aspects of laboratory investigation in health and disease that focuses on the causes, manifestations and diagnosis of disease. Pathology can be subdivided.
Biochemistry is the branch of science concerned with the chemical and physiochemical processes and substances which occur within living organisms. Biochemistry test refers to the chemical identification of a particular enzyme or protein in bodily fluid samples like blood, urine, CSF etc. The entire range of biochemistry tests is available in our diagnostic centres.
Serology is the scientific study of serum and other bodily fluids. It refers to the diagnostic identification of antibodies in the serum. Latest serological antibody assays to rapid molecular-based techniques such as real-time PCR.

Histopathology is the examination of tissues from the body under a microscope to spot the signs and characteristics of the disease. Histology is the study of tissues, and pathology is the study of disease. A histopathology report is sometimes called a biopsy report or a pathology report.

Clinical pathology deals with the essential nature of a disease, especially of the changes in body tissues and organs caused by the disease. An entire range of clinical pathology tests is conducted in our diagnostic centres.

Kwadaso next to SDA Hospital, Danyame next to Ultimate FM, Tafo opposite Tafo Gov. Hospital, Kumasi, Ghana
info@totalitehealth.comKwadaso next to SDA Hospital, Danyame next to Ultimate FM, Tafo opposite Tafo Gov. Hospital, Kumasi, Ghana
info@totalitehealth.comKwadaso next to SDA Hospital, Danyame next to Ultimate FM, Tafo opposite Tafo Gov. Hospital, Kumasi, Ghana
info@totalitehealth.comKwadaso next to SDA Hospital, Danyame next to Ultimate FM, Tafo opposite Tafo Gov. Hospital, Kumasi, Ghana
info@totalitehealth.com